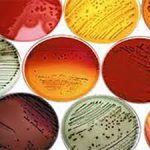
MRS

MRS براث
تومان850.000
محیط کشت MRS حاوی منابع کربن ، نیتروژن و ویتامین ها برای حمایت از رشد لاکتوباسیل ها و موجودات دیگر است.
پروتئین پپتون و عصاره گاو ترکیبات ازته و کربن را فراهم می کند. عصاره مخمر ویتامین B کمپلکس را تأمین می کند و دکستروز به عنوان یک کربوهیدرات و منبع انرژی عمل می کند. Polysorbate 80 یک سورفاکتانت است.
جذب مواد مغذی توسط لاکتوباسیل ها را تسهیل می کند و اسیدهای چرب مورد نیاز برای متابولیسم لاکتوباسیل ها را تأمین می کند. این یک ماده انتخابی است که از استات سدیم و سیترات آمونیوم برای جلوگیری از رشد بیش از حد موجودات زنده استفاده می کند.
MRS براث
MRS براث یک محیط کشت غنی و اختصاصی است که بهطور ویژه برای رشد و تکثیر باکتریهای لاکتیک اسید طراحی شده است. این محیط بهدلیل ترکیبات مغذی و شرایط بهینهای که فراهم میکند، بهعنوان یک ابزار ضروری در تحقیقات میکروبیولوژی و صنایع غذایی مورد استفاده قرار میگیرد.
ویژگیها:
-
ترکیب مغذی کامل:
- محیط کشت MRS براث شامل ترکیبات مغذی همچون پروتئینها، ویتامینها و مواد معدنی است که برای رشد باکتریهای لاکتیک اسید ضروری هستند.
-
pH بهینه:
- این محیط بهطور خاص برای حفظ pH مناسب برای رشد باکتریهای لاکتیک اسید تنظیم شده است، که باعث افزایش کیفیت کشت میشود.
-
عملکرد سریع:
- باکتریها در محیط کشت MRS براث به سرعت و بهطور مؤثر رشد میکنند، که این ویژگی برای آزمایشها و تحقیقات علمی بسیار مهم است
- این محیط کشت بهطور گسترده در آزمایشگاههای میکروبیولوژی و همچنین در صنایع غذایی برای کنترل کیفیت و تجزیه و تحلیل محصولات غذایی استفاده میشود.
کاربردهاMRS براث:
-
تحقیقات میکروبی:
- محیط کشت MRS براث برای مطالعه خصوصیات و رفتار باکتریهای لاکتیک اسید در پروژههای تحقیقاتی مختلف استفاده میشود.
-
صنایع غذایی:
- در کنترل کیفیت محصولات لبنی و دیگر محصولات غذایی، این محیط کشت بهعنوان ابزاری کلیدی به کار میرود.
-
آزمایشگاههای آموزشی:
- در دورههای آموزشی مرتبط با میکروبیولوژی، این محیط کشت بهعنوان یک ابزار آموزشی مؤثر به کار میرود.
مزایاMRS براث:
-
افزایش دقت نتایج:
- با استفاده از محیط کشت MRS براث، دقت در نتایج آزمایشها و تحقیقات افزایش مییابد.
-
سازگاری با انواع باکتریها:
- این محیط کشت قابلیت رشد انواع مختلف باکتریهای لاکتیک اسید را داراست و بهاینترتیب در تحقیقات متنوع قابل استفاده است.
-
سهولت در استفاده:
- آمادهسازی و استفاده از محیط کشت MRS براث ساده و سریع است، که این امر به تسهیل فرآیندهای آزمایشگاهی کمک میکند.
نتیجهگیری:
محیط کشت MRS براث یک انتخاب عالی برای هر آزمایشگاه میکروبی و صنعتی است. با ویژگیهای منحصر به فرد خود، این محیط کشت به شما کمک میکند تا باکتریهای لاکتیک اسید را بهطور مؤثر و دقیق کشت کنید و نتایج قابل اعتمادی را کسب نمایید.
مانند سایر محیط کشت های دیگر این محصول را می توان در بخش موادشیمیایی از سایت آریا پیرکس در مقادیر مختلف 100 گرمی و 500 گرمی تهیه کرد.

دیدگاهها
هیچ دیدگاهی برای این محصول نوشته نشده است.